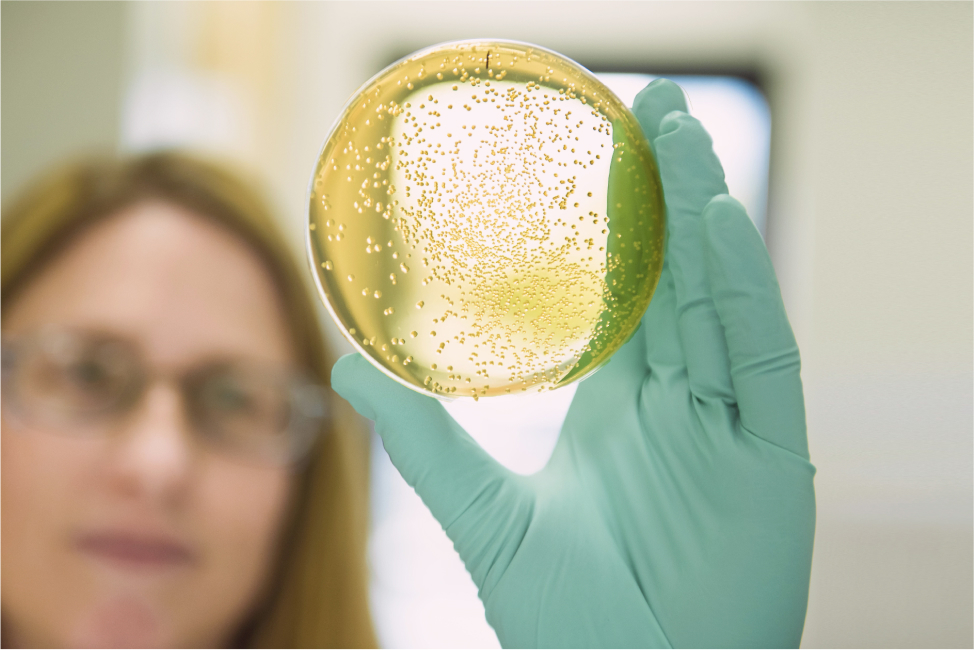
vartuppdrag1png

Gilead är ett globalt biofarmaceutiskt företag som strävat efter och uppnått medicinska genombrott i mer än 30 år, med målet att skapa en friskare värld för alla människor. Företaget fokuserar på att utveckla innovativa läkemedel för att förebygga och behandla livshotande sjukdomar samt tillgodose medicinska behov inom onkologi och virologi, inklusive HIV och virushepatit. Med huvudkontoret i Foster City, USA, är Gilead verksamt i fler än 35 länder världen över. 2008 etablerades företaget i Norden med huvudkontor i Stockholm.